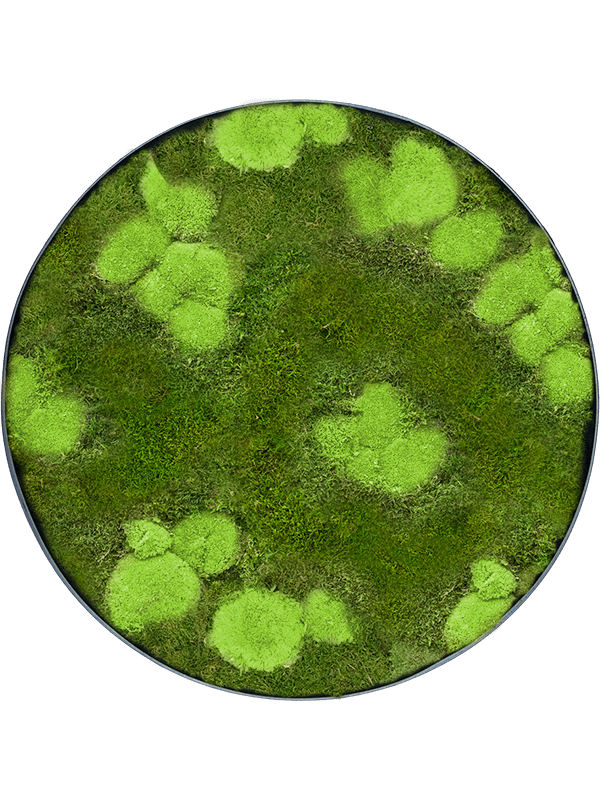

Mechový obraz Nova rám antracit 30% Ball- and 70% flat moss (70x5cm)
Hotový a připravený Mechový obraz Nova rám antracit 30% Ball- and 70% flat moss (70x5cm) je vhodný jako dekorace na zeď. Zobrazit více
| Kód: | Kód: CMSS01062 |
Zboží naskladňujeme každý týden. Abychom vaši objednávku doručili v následujícím týdnu (úterý až čtvrtek), proveďte ji prosím do čtvrtka do 14:00. Tento termín doručení platí pro Liberec, Mladou Boleslav, Prahu a Středočeský kraj. Do ostatních regionů doručujeme v rozmezí 5 až 30 dní. Přesný čas nejbližší uzávěrky vidíte vždy v horní zelené liště našeho webu.
Dotazy ohledně květináčů, doplňků a technického rázu mě kontaktujete: +420 739 960 870
| Průměr | 70 cm |
| Výška | 5 cm |
| Hrdlo květináče | 69 cm |
| Vnitřní výška - pro bal | 4 cm |
| Hmotnost | 4.48 kg |
| Prodej po | 1 ks |
| Země původu | NL |
Mohlo by Vás zajímat
Mechový obraz Nova rám Anthracite-concrete 100% Flat moss (30x5cm)
Dostupných je: > 52 ksMechový obraz Nova rám antracit 100% lišejník (Light Grass Green) (60x5cm)
Dostupných je: > 80 ksMechový obraz Nova rám antracit 100% lišejník (Natural) (70x5cm)
Dostupných je: > 50 ksHairmoss Forest green (balení probox = ca. 0,7 m²)
Dostupných je: > 90 ksDalší kusy 04.06.2026

Nakupte za 5 000 Kč
Nakupte za 5 000 Kč 
